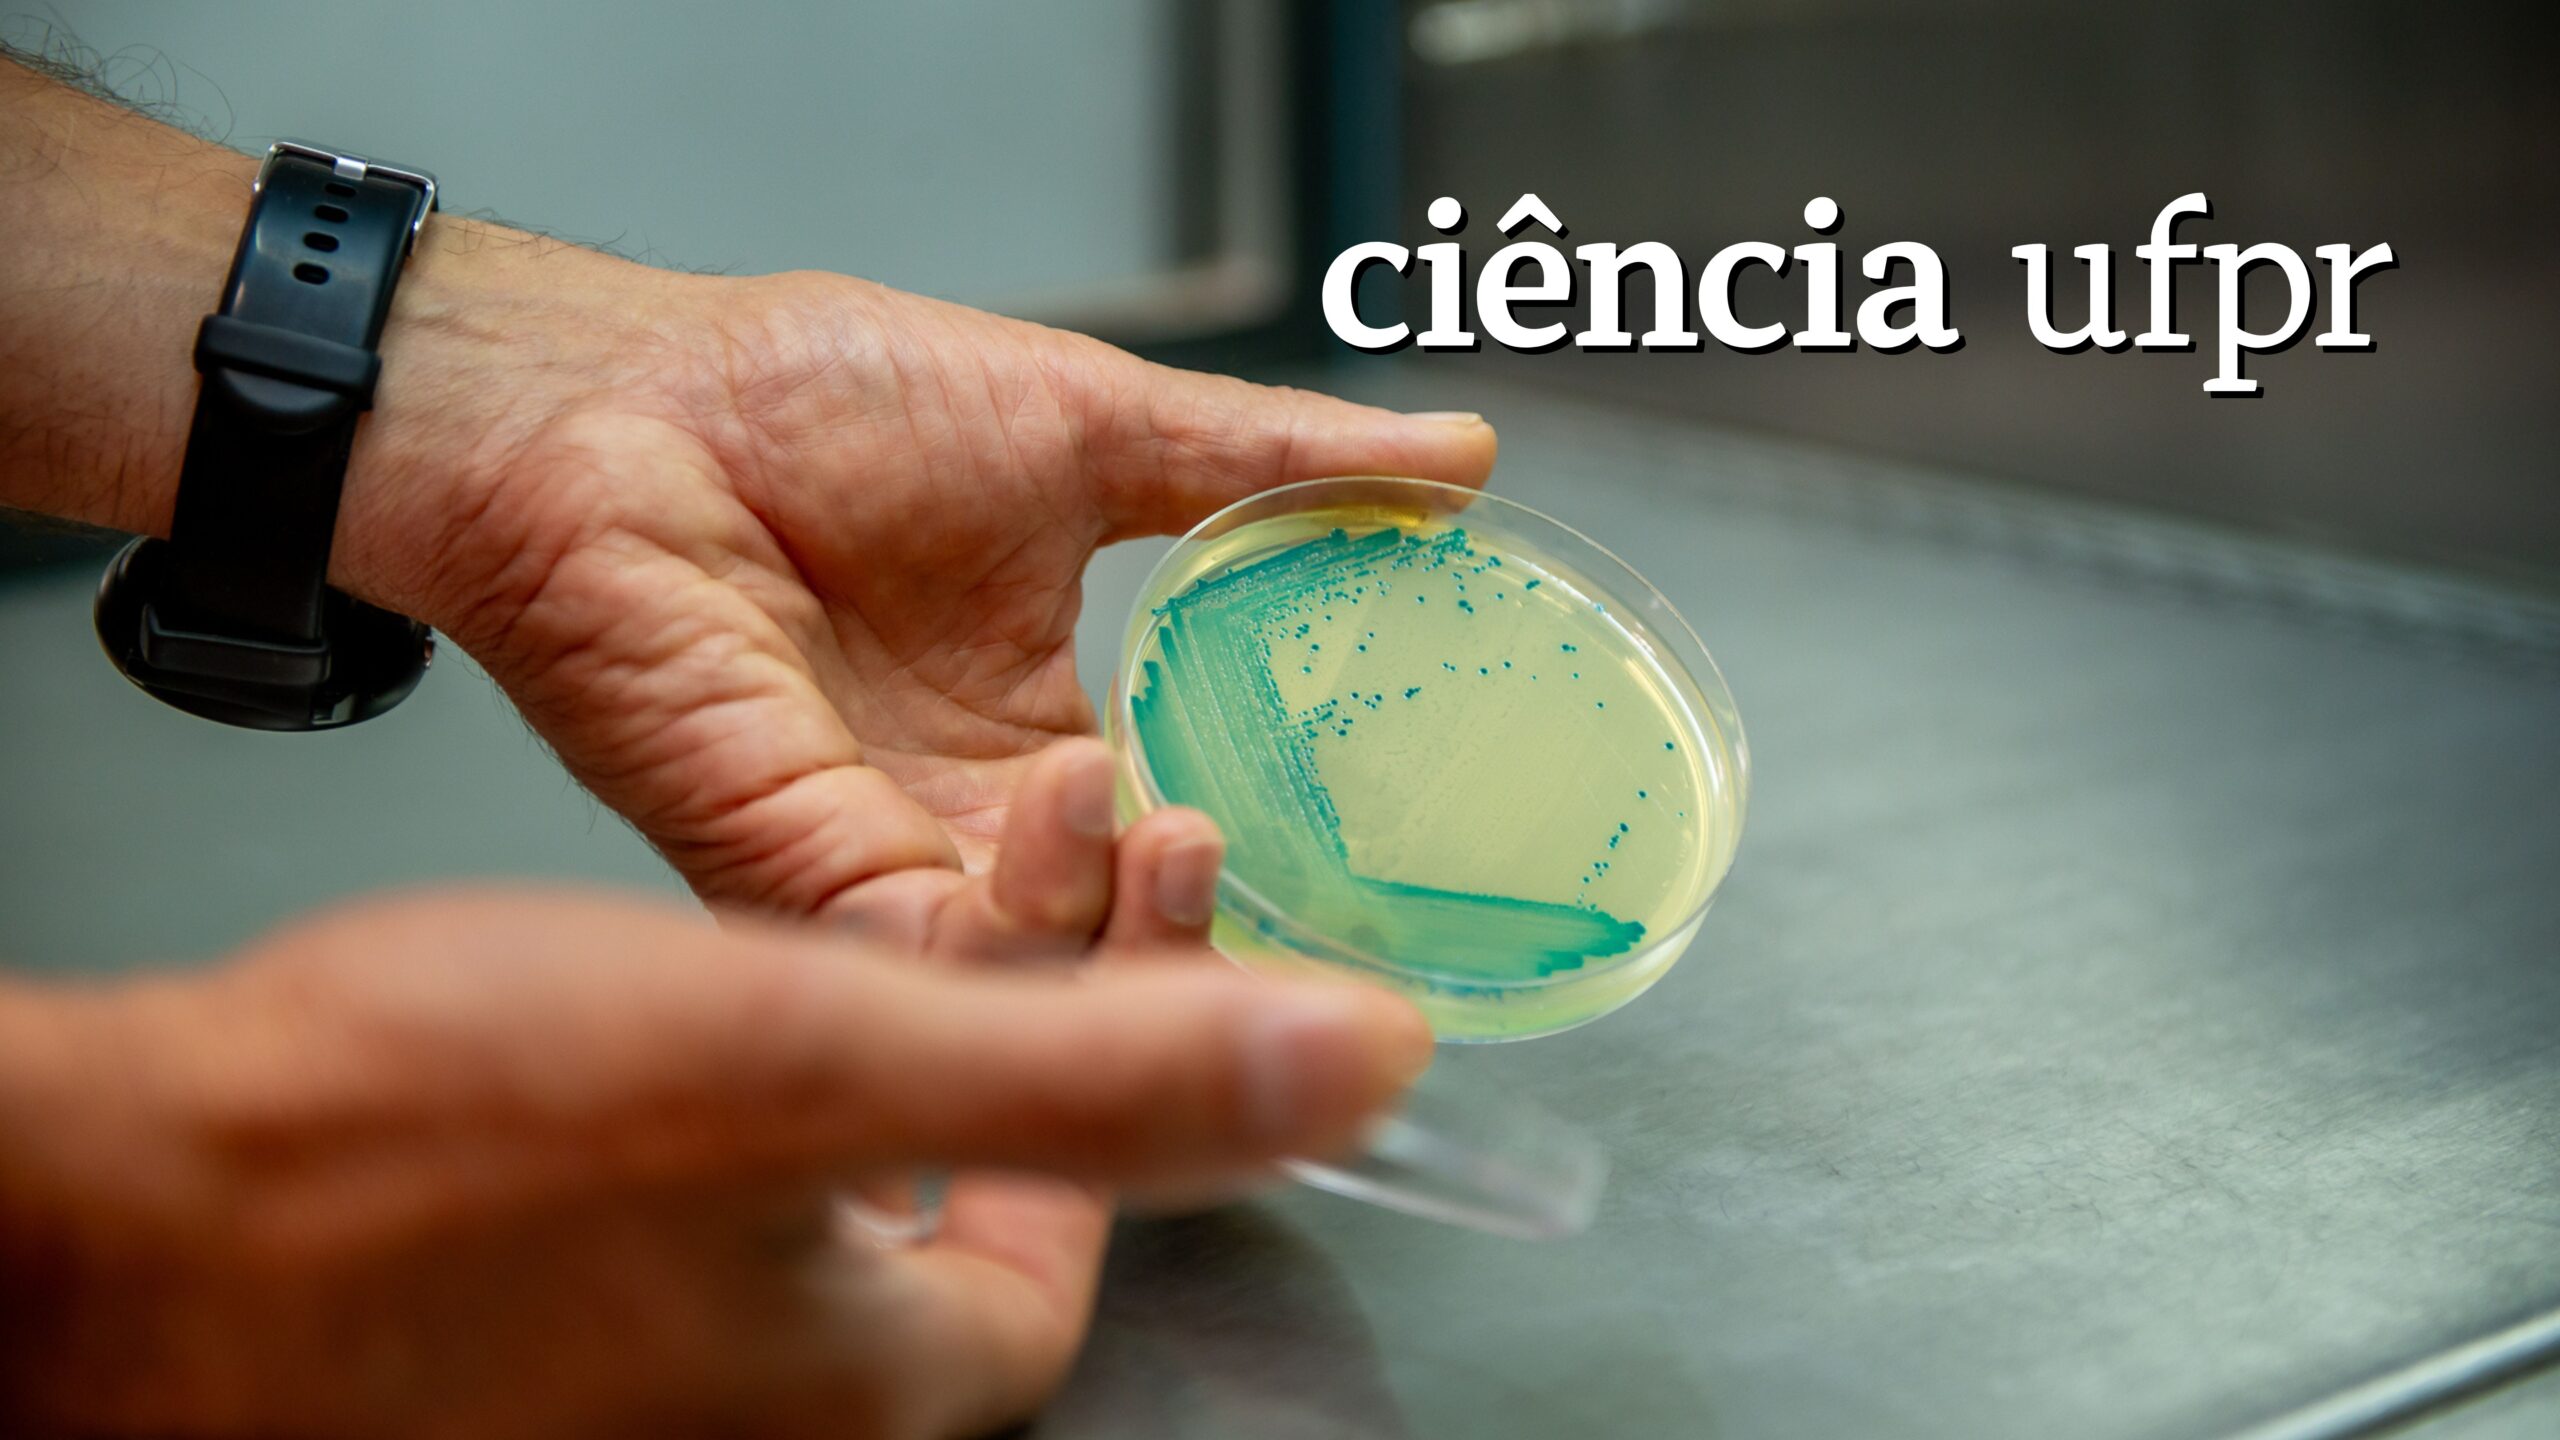

Ciência UFPR: Nova bactéria biotecnológica aumenta produtividade do milho
Pesquisadores do Núcleo de Fixação Biológica de Nitrogênio da UFPR trabalharam décadas para criar inoculante que alavanca produção na agricultura
Bactérias fixadoras de nitrogênio são microrganismos encontrados naturalmente em raízes de plantas como milho, trigo, cana-de-açúcar e arroz. Seu papel de fixar nitrogênio e liberá-lo para a planta permite a redução do uso de fertilizantes, um dos insumos mais caros na agricultura. Ainda que descobertas há cerca de 130 anos, estudos recentes têm ampliado as possibilidades de sua utilização e aprimorado seu desempenho.
É o caso da bactéria HM053, uma cepa que pertence à espécie Azospirillum brasilense, que foi selecionada pelo professor do Programa de Pós-Graduação em Bioquímica da Universidade Federal do Paraná (UFPR), Fábio de Oliveira Pedrosa, e seu então aluno de mestrado, Hidevaldo Bueno Machado.
Isso ocorreu em 1987, no Núcleo de Fixação Biológica de Nitrogênio, por uma técnica chamada evolução adaptativa. Essa estirpe tem uma capacidade de fixar nitrogênio aumentada muitas vezes em decorrência do processo de seleção.
“A partir do isolamento e da caracterização de mutantes de Azospirillum brasilense resistentes a etilenodiamina, selecionamos quatro estirpes para caracterização bioquímica, fisiológica e genética. Todas foram capazes de fixar nitrogênio”, pontua Pedrosa.
Leia a matéria completa, com infográfico e fotos, no site da Ciência UFPR
Foto de destaque: Marcos Solivan/Sucom UFPR
Conheça e siga os canais da Ciência UFPR aqui